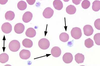
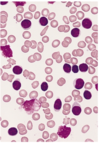

MSK/Hematology Flashcards
(88 cards)
This antibiotic can cause tendon rupture
floroquinolones (ciprofloxacin)
CML (chronic myeloid leukemia)
9:22 translocation. BCR-ABL translocation that constituitly activates tyrosine kinase. Tx with gleevec.
Bacteria causing Lyme Disease
Borrelia Burgdorferi, a corkscrew-shaped spirochete that causes lyme disease. The natural reservoir is the mouse and is transmitted by the Ixodes deer tick.

Cause for albinism
recessive mutation the gene for tyrosinase (converts DOPA –> Melanin)
Staph Toxic Shock Syndrome
Can happen when leave a tampon in for too long. The S.aureus exotoxin is a superantigen. Binds to MHC II and T-cell receptor causing polyclonal T-cell activation.
Dx: it is often not identified until desquamation of the palms occurs

Ankylosing Spondylitis
90% positive for HLA B27. Symmetric involvement of spine or sacroiliac joints. Often see “bamboo spine” tx: Adalimumab (TNF-alpha), infliximab (TNF-alpha)
Osteoporosis lab findings for Ca, Phos, Alkaline Phosphatase
ALL NORMAL
Paget disease lab findings (Ca, P, Alk Phos)
Normal Ca, Normal Phos, Elevated Alk Phos
CML translocation and associated problem and tx
9:22 BCR-ABL (philadelphia). constitutively active Tyrosine Kinase. Treat with Imatinib=Gleevec (a tyrosine Kinase inhibitor)
CREST syndrome. What is it and what does it stand for
Limited Scleroderma: anticentromere autoantibody C: calcinosis R: Reynaud E: esophageal dysmotility S: sclerodactyl (thickening of skin of fingers/toes) T: telangectasia (small red skin marks from abnormally dilated blood vessels)

Reactive arthritis triad and when is it seen
- Conjunctivitis 2. Urethritis 3. Arthritis “Can’t see, can’t pee, can’t bend my knee” Seen post GI/Chlamydia Positive for HLA-B27
Hereditary spherocytosis smear
defect in RBC membrane that shows small RBC with lack of central pallor and abundant reticulocytes Howell-Jolly bodies (fragments of nuclear material in RBC are present)
Polymyositis
subacute inflammatory myopathy with CD8+ T cells and macrophages progressive symmetrical proximal muscle weakness -like dermatomyositis but without SLE rash

Follicular Lymphoma
neoplastic proliferation of SMALL B Cells that are CD20+ Driven by 14;18 translocation 14: Ig heavy chain 18: BCL2 (get inhibition of apoptosis) Can progress to DLBCL (diffuse large cell) Tx: rituximab

14:18 translocation
Follicular lymphoma (get inhibition of apoptosis due to overexpression of BCL2)
Mantle Cell Lymphoma
neoplastic proliferation of SMALL B cells (CD20) that expands the mantle zone. Driven by t(11;14) 11: Cyclin D1 gene (overexpression of D1 promotes G –> S transition in cell cycle 14: Ig heavy chain
Marginal Zone Lymphoma
neoplastic proliferation of SMALL B cells (CD20) that expands the marginal zone. Associated with chronic inflammatory states such as Hashimoto thyroiditis, Sjogren syndrome (parotid), H. Pylori gastritis (MALToma) If treat the gastric MALToma H. Pylori, can cure lymphoma (only lymphoma that can cure with abx)

Burkitt Lymphoma
INTERMEDIATE sized B cells (CD20). Associated with EBV (a herpesvirus) Two types: 1. African- extranodal mass in jaw 2. Sporatic- shows up in abdomen t(8;14) translocation 8: c-myc (oncogene that is overexpressed that causes cell growth) 14: Ig heavy chain Starry sky appearance on microscope (due to high mitotic rate)
Diffuse large B-cell lymphoma
Neoplastic proliferation of LARGE B-Cells (CD20) Most common form of NHL Clinically aggressive (makes sense since the cells are not well differentiated) -Arises sporadically or can develop from Follicular lymphoma
- One risk factor for developing Hodgkin Lymphoma is immunosuppression (can occur in HIV or immunosuppressant drugs such as those for IBD)
- Increasing age is also a risk factor
Hodgkin Lymphoma
Neoplastic proliferation of Reed-Sternberg cells (owl eye nuclei). CD15+, CD30+ RS cells secrete cytokines! Results in B-sx (f/c, wt loss, night sweats) Bulk of tumor is reactive cells that attracted by cytokines.

4 types of Hodgkin Lymphoma
- Nodular Sclerosis (most common). Presents with cervical or mediastinal lymph node in young female.
- Lymphocyte-rich (best prognosis) *This is the type that is associated with B-symptoms (fever, chills, night sweats)
- Mixed Cellularity (abundant eosinophils via IL-5). Has the highest number of Reed Sternberg cells
- Lymphocyte depleted (worst prognosis)
Multiple Myeloma (overview)
Malignant proliferation of plasma cells in bone marrow. Most common primary malignancy of bone. High serum IL-6 present that stimulates plasma cell growth.
-Plasma cells have abundant Rough Endoplasmic Reticulum (the site of synthesis of secretory proteins)

Multiple Myeloma (clinical features) 6 of them
- Bone pain with hypercalcemia due to activation of RANK on osteoclasts (causes lytic lesions)
- Elevated serum protein (M-spike, due to IgG or IgA) 3. Increased risk infection (due to lack of antigenic diversity)
- Rouleaux formation of RBC (decreased charge btw RBC)
- Free light chains –> amyloidosis
- Proteinuria –> kidney failure (myeloma kidney)

Monoclonal Gammopathy of Undetermined Significance (MGUS)
Increased serum protein with M-spike but NO other findings of typical multiple myeloma. Common in elderly (5% of 70 year olds). Can be thought of as pre-myeloma (although only 1% develop each year to full fledged multiple myeloma)